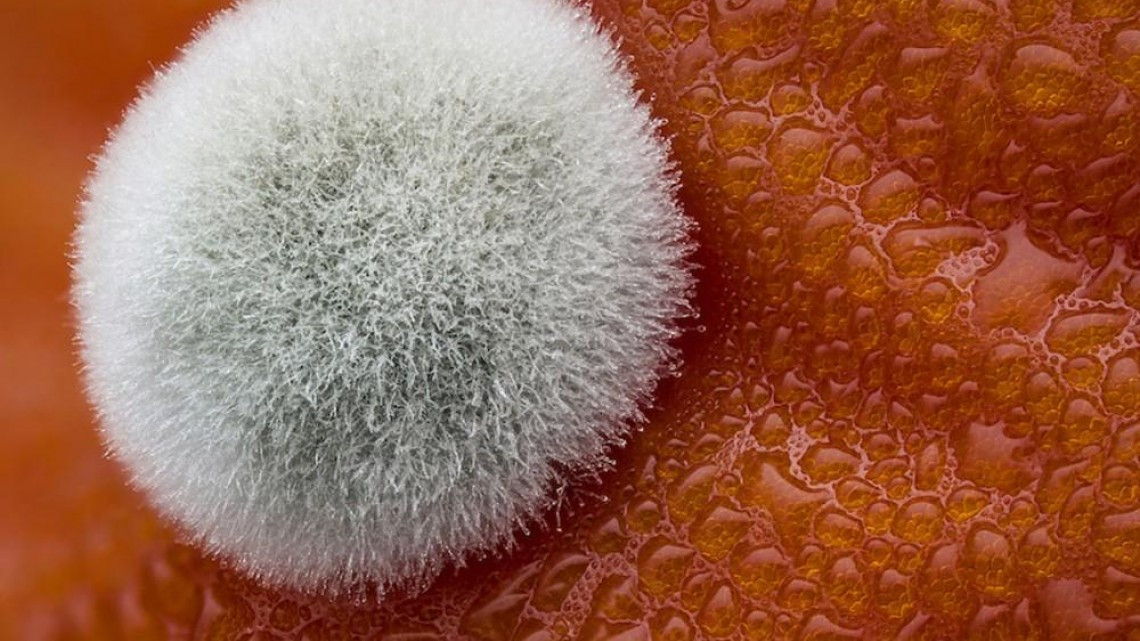
Estas microscópicas imágenes te sorprenderán

Estas microscópicas imágenes te sorprenderán
Por: Staff NotiGape
22/03/2018 05:06

1/21
El mundo microscópico es igual de interesante como espectacular, que puede llegar a mostrarnos las sorprendentes dimensiones ocultas que existen, esto a través de las llamadas micrografías.
Es el concurso de imágenes Nikon Small World quien reconoce estas y entrega cada año una serie de premios a los investigadores y aficionados que capturan las imágenes microscópicas más impresionantes, siendo este considerado el foro principal para mostrar la belleza y la complejidad de la vida vista a través de la luz del microscopio.
Este pasado 2017, el Nikon Small World alcanzó su 37º edición.






